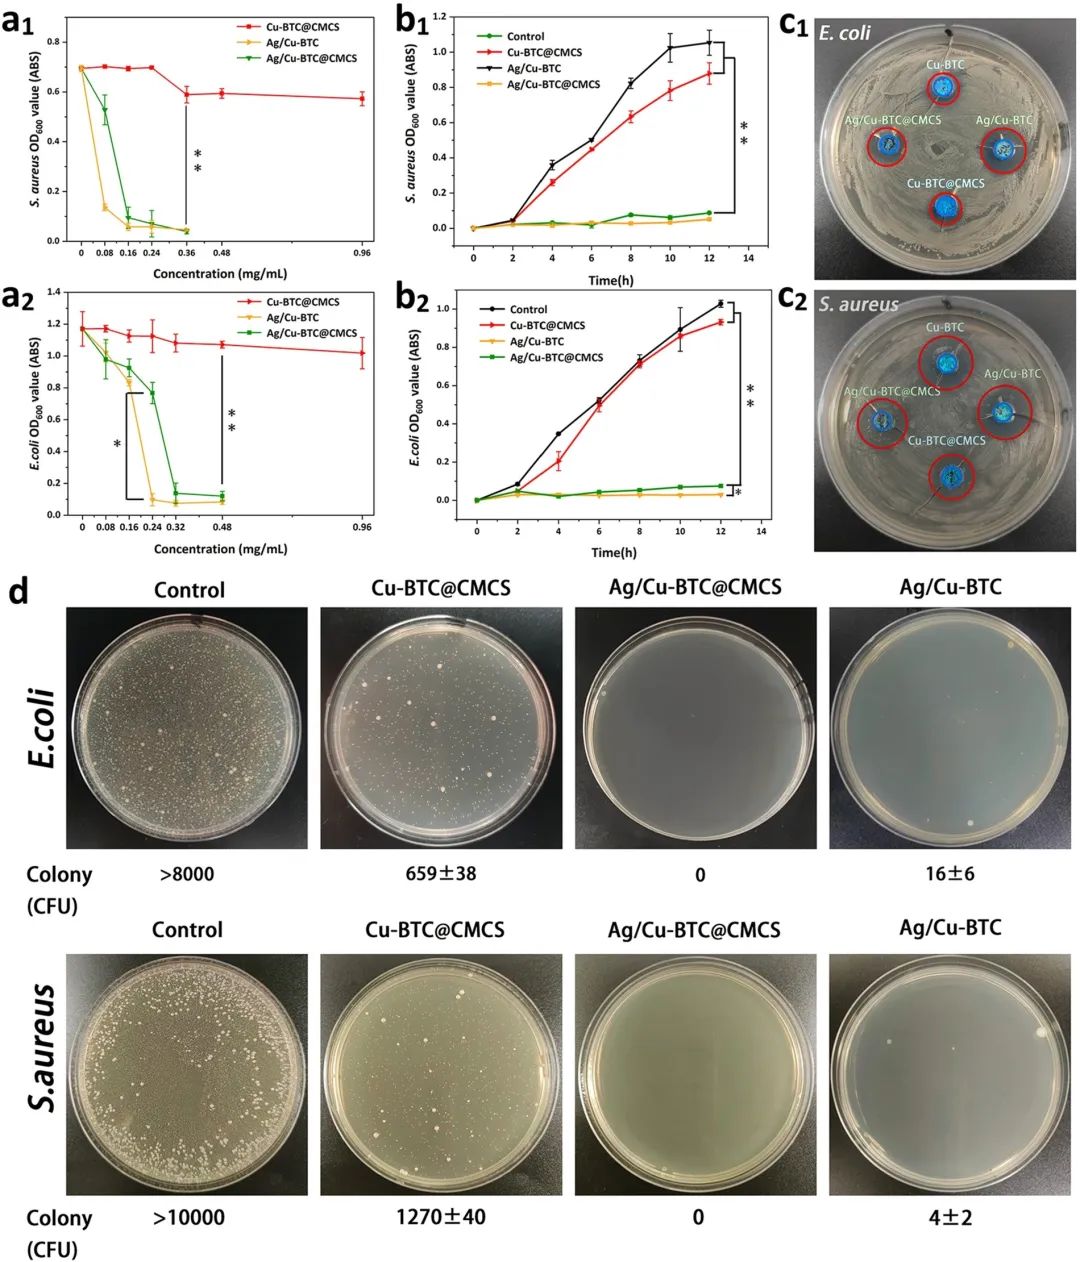
Ag/Cu-BTC@CMCS的抗菌性能 Ag/Cu-BTC@CMCS的抗菌性能

3348
2022-12-01
颗粒在线讯:通过水体环境传播的病原体一直是人类生命健康的重大威胁。目前,最常用的水消毒剂是次氯酸钠、液氯、三氯异氰尿酸等含氯化学品。这些消毒剂易分解,须频繁投药,且都易产生有毒副产物。尤其在循环用水场景(如游泳池),水中氯化物副产物有逐渐积累的风险。因此,发展更加安全且效果持久的新型水体抗菌材料对公共卫生安全的防护意义重大。近年来,以金属离子作为抗菌成分的复合材料已广泛应用于医用敷料、抗菌涂层等领域。然而这类复合材料通常具有金属离子暴释的风险,既不能保证较长的使用期限,又导致较高的生物安全隐患,因此很少被用于水环境的杀菌消毒。另外,单一种类的金属离子在抗菌应用中也各有缺陷,如含银离子易变色发黑,而铜锌等离子抗菌效率有限等问题。
针对上述问题,近日,广西大学林宝凤教授团队通过将天然高分子与MOFs结合并进行金属离子后合成交换(PSE),成功构建了一种可用于水体抗菌的金属离子载体。天然高分子和双金属MOF同时作为两种金属离子的“仓库”,为抗菌应用提供了适宜的离子释放性能,并通过两种金属离子的组合实现的协同抗菌作用提供了出色的抗菌性能。该复合材料实现了对模拟游泳池水的持续抑菌效果,并显示出高的生物安全性和可重复利用性能,为新型水体杀菌剂的设计和商业应用提供了新的见解和策略。该工作以“Hybridization of carboxymethyl chitosan with bimetallic MOFs to construct renewable metal ion “warehouses” with rapid sterilization and long-term antibacterial effects”为题发表于《Carbohydrate Polymers》。

【双金属复合材料的构建与表征】

图1. 双金属复合材料Ag/Cu-BTC@CMCS的构建
在复合材料的设计中(图1),首先通过Cu-MOFs在羧甲基壳聚糖(CMCS)上的原位生长合成了Cu-BTC@CMCS材料,然后在PSE过程中用银离子取代材料中的一部分铜离子,从而获得双金属Ag/Cu-BTC@CMCS复合珠。综合表征(图2)证明了材料的成功制备,并且证实了银离子和铜离子在CMCS上和MOFs组分中都有一定分布。在金属离子释放性能的测试中,复合材料结合了纯的双金属MOFs以及简单的双金属交联CMCS材料的优点,显示出快速的初期释放和持久的长期释放性能。因此,该复合材料有望在抗菌领域中表现出优异的抗菌效果。

图2. Ag/Cu-BTC@CMCS的的结构表征
【Ag/Cu-BTC@CMCS的抗菌及再生性能】
图3. Ag/Cu-BTC@CMCS的抗菌性能
得益于两种金属离子的协同抗菌作用及材料独特的离子释放特点,Ag/Cu-BTC@CMCS复合珠具有相对较低的最低抑菌浓度(MICs),并可在2h内迅速灭杀超过99.9%的大肠杆菌和金黄色葡萄球菌。同时,持续抑菌能力在传统的金属交联高分子材料基础上有大幅提高,此外,复合材料展现出良好的可回收性和重复利用潜力。通过重新补充CMCS上被消耗的金属离子,复合材料具备3次以上的再生抗菌能力。以HeLa细胞为模型的细胞毒性实验结果表明复合材料用于水体消毒具有足够的安全性。

图4. Ag/Cu-BTC@CMCS的再生性能
【Ag/Cu-BTC@CMCS用于泳池水的消毒】

图5. 泳池水消毒灭菌应用
该团队将此复合材料应用于泳池水的消毒灭菌,结果表明Ag/Cu-BTC@CMCS在使用4h内即可灭杀模拟泳池水中的细菌,并在48h内将细菌数量持续抑制在卫生标准以内,且再生重复使用次数达到4次。在相同的水质条件下,Ag/Cu-BTC@CMCS所需的投放频率远低于次氯酸钠和三氯异氰尿酸。此外CMCS对金属离子的锚定作用保证了水中的金属离子浓度处在安全范围,进一步证明了材料出色的生物安全性。
【小结】
在这项工作中,通过原位生长和后合成交换策略,该团队设计合成了一类双金属MOFs@CMCS复合材料。材料中CMCS组分和MOFs组分均可作为银离子和铜离子的载体,且两种载体的离子释放特性互为补充,使材料具备出色的抗菌性能,同时有效避免了金属离子过量释放的安全隐患,可用于泳池水等水体环境的杀菌消毒。此工作为金属离子的储存和可控释放提供了新思路,并揭示了相关材料的水体消杀应用潜力。此外,文中展示的双金属MOFs@天然高分子复合材料的制备策略具有可控性和普适性,可用于制备多种新型双金属复合材料。因此,Ag/Cu-BTC@CMCS复合材料有望作为一种新型金属离子释放载体,用于公共卫生安全的防护。相关技术已申请中国发明专利( “一种水体消毒抗菌材料及其制备方法和应用”,申请号202211206394.7)。
该论文的通讯作者为广西大学化学化工学院林宝凤教授,第一作者为硕士研究生李昊。该研究得到国家自然科学基金(51863001和22175045)和广西自然科学基金重点项目(2021GXNSFDA220005)的支持。
来源:高分子科学前沿
版权与免责声明:
(1) 凡本网注明"来源:颗粒在线"的所有作品,版权均属于颗粒在线,未经本网授权不得转载、摘编或利用其它方式使用上述作品。已获本网授权的作品,应在授权范围内使用,并注明"来源:颗粒在线"。违反上述声明者,本网将追究相关法律责任。
(2)本网凡注明"来源:xxx(非颗粒在线)"的作品,均转载自其它媒体,转载目的在于传递更多信息,并不代表本网赞同其观点和对其真实性负责,且不承担此类作品侵权行为的直接责任及连带责任。其他媒体、网站或个人从本网下载使用,必须保留本网注明的"稿件来源",并自负版权等法律责任。
(3)如涉及作品内容、版权等问题,请在作品发表之日起一周内与本网联系,否则视为放弃相关权利。